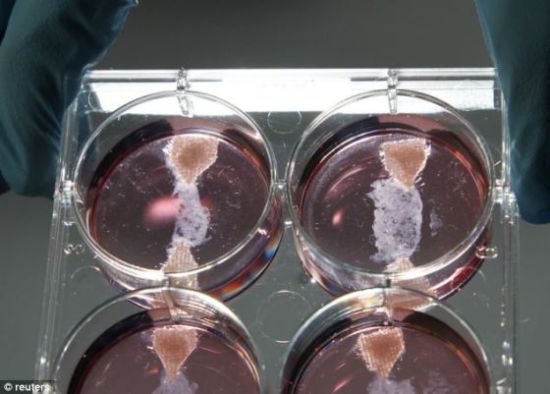

中新网8月7日电 据香港《文汇报》报道,荷兰科学家于去年在实验室培植出“试管肉”,5日,当地一批科学家、厨师及艺术家连手推出全球首本试管肉食谱《试管肉烹饪书》,里面包含的菜肴千奇百怪,点餐时需要不少勇气。
据报道,食谱中有烧速龙脚、炸渡渡鸟及试管蚝等菜肴。烧速龙脚是以鸡肉纤维,围绕在3D立体打印的速龙骨头培植,准确地重塑速龙脚,食谱建议“上菜前让速龙脚放置室温15分钟”。
炸渡渡鸟则是利用17世纪已绝种的毛里求斯渡渡鸟样本,培植渡渡鸟肉并制作炸鸟块。食谱内并非每种食物皆容易被接受,由肉类干细胞培植的试管蚝就有点令人反胃,但食谱强调客人可决定蚝的味道,例如可烹制成偏咸的海水风味。
科学家兼哲学家范门斯福尔特表示,食谱并非要推广试管肉或改变未来饮食模式,而是想呈现饮食文化有不同选择,旨在探索试管肉的潜力,呈现试管肉上菜时的模样。(中新网)
编辑:WN154
新闻来源:http://www.wokeji.com/tupian/jrtj/201408/t20140815_793414.shtml

留言